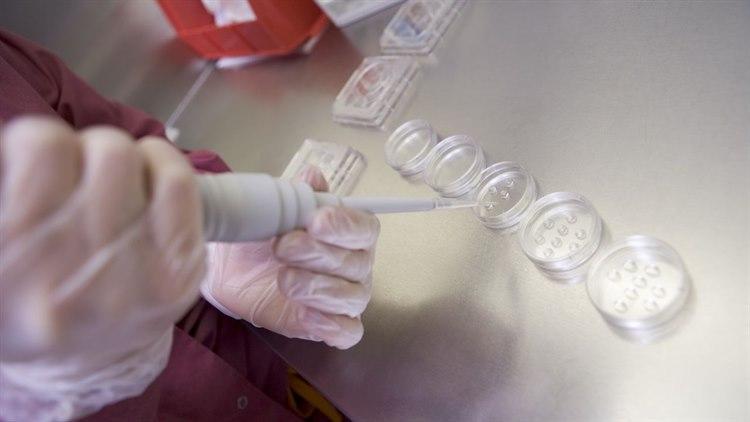
Illustrasjonsfoto: Colourbox

Ufrivillig barnløshet, å leve med
- Jeg har fått mange kommentarer om at den biologiske klokka tikker. Det er vanskelig når jeg allerede legger sånn press på meg selv, sier "Anne". Hun har forsøkt å bli gravid i seks år - uten en eneste positiv graviditetstest.
Av:
Merethe Kvam, journalist. Godkjent av medisinsk redaktør.
Sist oppdatert:
14. feb. 2016
Artikkelen er mer enn to år gammel og kan inneholde utdatert informasjon
I Norge er det omtrent 3000 par hvert år som vil få problemer med å oppnå graviditet. For et gjennomsnittlig par der kvinnen er under 35 år, vil det ta fire til seks måneder før de oppnår graviditet. Det er ikke uvanlig at det tar opptil to år å bli gravid.
Forsøkt å bli gravid i seks år
"Anne" (30) har ønsket seg barn i mange år. Hun og samboeren har forsøkt å bli gravide i snart tre år, men før den tid hadde også hun og eks-samboeren flere års forsøk bak seg.
- Jeg har forsøkt å bli gravid siden jeg var 24 år. Jeg og noen venninner hadde planlagt å bli gravide på samme tid, men slik ble det ikke, sier Anne.
Overraskelsen var stor da stadig flere i venninnegjengen ble gravide, men ikke hun. I 2012, da hun var 26 år, søkte hun hjelp hos fastlegen for første gang.
- Da var det allerede mye som hadde begynt å skurre i forholdet mellom meg og min eks-samboer. Utredningen varte i ett år. Det gikk veldig sakte, og vi fikk aldri svar på hva som var galt. Jeg satt igjen med mange ubesvarte spørsmål, sier Anne.
I forbindelse med utredningen ble det tatt blodprøver og innvendig ultralyd.
- I tillegg fikk jeg prøve Pergotime (som stimulerer kvinnens eggproduksjon). De var ikke interesserte i å undersøke mer, sier Anne.
Vet fortsatt ikke hvorfor
[imported]Da forholdet tok slutt valgte hun selv å oppsøke en privat klinikk for å få den ekspertisen hun trengte.
Gjennom den private klinikken fikk hun undersøkt om egglederne var tette, og det ble tatt blodprøver gjennom en hel syklus. Den private klinikken fant heller ingenting galt.
- I begynnelsen var det et problem at jeg ikke visste hvorfor det ikke virket hos meg, men hos alle venninnene mine. Men når du har kommet dit hen at du har startet med IVF (in vitro fertilisering - at egget befruktes utenfor kvinnens kropp, for så å plasseres i livmoren), så ser ikke behandlerne på dette som negativt. Dersom de for eksempel hadde funnet ut at jeg hadde kommet i tidlig overgangsalder og ikke produserte egg, så hadde det vært noe helt annet. Nå har jeg slått meg mer til ro med at vi ikke vet. Underveis har det likevel plaget meg veldig. Noen venner sa at det var min egen feil, at det var fordi jeg stresset for mye. Jeg stresset kanskje litt i starten, men du går ikke rundt og er konstant stresset i seks år, sier Anne.
- Føler at det er min feil
I de tre årene hun har vært sammen med sin nåværende samboer, har de ikke brukt prevensjon. Da hun og samboeren valgte å gå videre til prøverørsbehandling, følte Anne at det var naturlig å velge den private klinikken der hun tidligere hadde opplevd å få god hjelp.
Tidlig i utredningen fikk samboeren til Anne beskjed om at han hadde dårlig sædkvalitet. I etterkant viste dette seg å være feil, prøvesvarene slo slik ut på grunn av feber og influensa.
- Da de først sa det, opplevde jeg det nesten som en lettelse. At det ikke var min feil, på en måte. Da den årsaken ble fjernet, fikk jeg på nytt en følelse av at det var min feil. Det er ikke en god følelse å gå og kjenne på, sier hun.
Da hun var 16 år tok hun abort.
- I den situasjonen jeg var i da, kunne jeg ikke beholde barnet. Aborten ble tatt etter at svangerskapet hadde vart i 10-11 uker. Det føles veldig rart at den eneste gangen jeg har fått en positiv graviditetstest, var da jeg ikke ønsket det. Av og til klarer jeg ikke å la være å tenke... var det den muligheten jeg hadde? sier Anne.
Hun føler likevel at hun har vært heldig, som startet prosessen i ung alder.
- Dersom jeg hadde begynt prøvingen i 30-årene, hadde jeg vært mye seinere i prosessen nå. Å få barn er ingen rettighet, det er et ønske. Det er litt synd at ikke ufrivillig barnløshet er mer belyst. Jeg har mange venninner som venter lenge med å bli gravide. Jeg føler at de kanskje ikke vet hvor utfordrende det kan bli, sier Anne.
Adopsjon har hun ikke vurdert. Hun opplever at behovet for å bli gravid selv, kanskje er enda større nettopp fordi hun har vært gravid en gang.
Første IVF forsøk
Illustrasjonsfoto: ColourboxEn utfordring i denne prosessen har vært at paret er bosatt på et lite sted i utkant-Norge. For å få hjelp og behandling må de reise inn til nærmeste by, som heller ikke har stor kompetanse på dette feltet.
- Vi hadde det første IVF-forsøket før jul i 2015. Jeg vet at andre synes selve regimet med sprøyter hver dag og ultralyd på dag fem og dag ni er utfordrende, men da har du noe å forholde deg til. Gynekologen målte feil størrelse på folliklene, noe som førte til at klinikken trodde jeg hadde blitt overstimulert og måtte begynne på medisiner. I ettertid viste det seg at dette ikke stemte, sier Anne.
Paret kjørte deretter til klinikken i Trondheim. Det ble tatt ut 16 egg, men bare ett ble befruktet. De to neste ukene ble lange. Da graviditetstesten nok en gang viste negativt utslag, var det en voldsom nedtur.
- Jeg var ikke forberedt på at det skulle bli så tungt. Jeg hadde forsøkt å gjøre alt det riktige. Ikke drikke alkohol, ikke trene, ikke spise usunt. Jeg tenkte at dette kunne blitt tidenes julegave, sier hun.
Hun har ikke delt utfordringene med så mange andre, men samme dag som de fikk den siste, negative prøven, hadde de invitert til familiemiddag.
- Det var så tungt, og jeg klarte ikke å skjule at jeg hadde det vondt. Vi bestemte vi oss for å fortelle det til foreldrene våre. De har vært utrolig støttende, sier Anne.
Tungt å starte på nytt
Å bestemme seg for en ny runde med IVF, var vanskelig.
- Jeg hadde mye blødninger og plager. Men på Medicus, klinikken vi bruker, var de gode psykologer for oss, og vi fikk tett oppfølging. De sa at vi skulle legge en plan videre, og det gjorde vi. Det ga nokså ambivalente følelser. Det var tungt å begynne helt på nytt med sprøytene. Kroppen trengte litt tid til å normalisere seg, samtidig ville jeg også komme i gang så fort som mulig, sier hun.
At kjæresten hele tiden har vært oppmuntrende og positiv, har betydd mye. I tillegg har hun valgt ut ei venninne som hun snakker mye med.
- Jeg har ikke sagt det til flere. Mine venninner fortalte heller ikke meg om at de sluttet på p-pillen. Det er på en måte det samme. Noen ganger kan det være utfordrende, og jeg kommer i situasjoner der jeg må lyve. Mange vil ha meg med på trening eller lignende, men i den fasen vi er i nå, kan jeg ikke det, sier hun.
Hun opplever også å få sårende kommentarer - særlig fra de mer voksne og eldre kvinnene på hjemstedet.
- Jeg har fått mange kommentarer om at den biologiske klokka tikker. Det er vanskelig når jeg allerede legger sånn press på meg selv. Jeg trenger ikke press utenifra i tillegg. Det er rart også, i en tid hvor ufrivillig barnløshet er mer omtalt, at folk ikke tenker gjennom slike kommentarer, sier Anne.
Har håp
Illustrasjonsfoto: ColourboxNår NHI snakker med henne, er hun akkurat ferdig med andre runde med prøverørsbehandling. Første gang brukte de vanlig IVF, denne gangen har de forsøkt IVF med mikroinjeksjon (ICSI).
- Ved vanlig IVF settes egget og sædcellen i nærheten av hverandre, slik at befruktningen skjer av seg selv. Ved ICSI blir sædcellene injisert inn i egget. På forhånd har vi brukt Macs - en metode der de plukker ut de beste sædcellene, og Eeva, en inkubator som vurderer embryo tidlig. Ved denne teknologien filmer de og tar bilder, og velger slik ut de beste embryoene. Samtidig får embryoene være helt ifred, sier Anne.
Det er nå en og en halv uke til hun får svar på om hun ble gravid denne gangen.
- Dette er den mest utfordrende delen av prosessen. Jeg har håp, men denne gangen har jeg beina bedre plantet på jorda, sier hun.
Hun er sykmeldt fra jobben som lærer i en uke til. Selv om utfallet er uvisst, får behandlingen frem alle svangerskapssymptomene med kvalme, tretthet, slitenhet og oppblåsthet.
- Jeg ser hva de har
Det Anne opplever som mest krevende med å være ufrivillig barnløs, er at tiden går.
- Man har ikke overflod av egg, og jeg vet hvor viktig alder er i forhold til IVF. Det er også trist å tenke på at jeg kanskje ikke skal få oppleve å bli mor. Jeg er så heldig å være tante til to. Det er en glede, men også en sorg. Jeg ser hva de har. Mange venninner har fokusert på alt det jeg som barnløs kan gjøre. Da blir jeg litt irritert. Mens de ser på begrensningene med å ha barn, kjenner jeg på frykten for å kanskje aldri få oppleve det. Jeg ønsker meg en familie. Samfunnet er litt sånn, du må se på hva du har og være glad for det. Å få barn er noe som er så fastgrodd i mange av oss. Det er i allefall et sterkt ønske hos meg. Da er det veldig tungt å vite at vi kanskje ikke får det. Det fleste ting kan du bestemme selv. Etter aborten var jeg veldig nøye med at jeg skulle gjøre alt i livet mitt "riktig". Ta en utdannelse, få jobb, finne en kjæreste og skape et trygt hjem for så å stifte familie. Alt kunne jeg kontrollere og bestemme selv, utenom det å få barn. I dag ser jeg at ikke alt kan kontrolleres. Det er tungt å fordøye, men kanskje er det en bra lærdom i det og, sier "Anne".